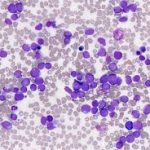

ACUTE MYELOID LEUKAEMIA (AML)
November 13, 2022
CHRONIC MYELOID LEUKAEMIA (CLL)
November 13, 2022Acute Lymphoblastic Leukaemia is a malignant disorder of the bone marrow that affects white blood cells (mainly the lymphocytes). Bone marrow only releases white blood cells after they are fully developed, but in this condition, it releases a large number of white blood cells that are not fully developed (known as blasts).
The increase in several blasts reduces the number of red blood cells and platelets in circulation. It affects both children and adults but mostly children. It is also the most common type of childhood cancer.
ALL is a result of DNA mutation but the exact cause of the mutation is unclear. Risk factors include obesity, smoking, previous chemotherapy, a weakened immune system and a genetic disorder. This condition progresses quickly and requires immediate treatment.
Some of the symptoms are pale skin, fatigue, unintended weight loss, unusual and frequent bleeding, high temperature, recurring infections, bone pain, shortness of breath, night sweats, swollen lymph nodes, headaches, seizures and abdominal pain due to enlarged liver or spleen.
Laboratory diagnosis for ALL involves Blood tests (Full Blood Count), Bone marrow Biopsy, Imaging tests and Cerebrospinal Fluid test (lumbar puncture test).
Treatment involves Chemotherapy, Blood transfusion, Radiation therapy, Targeted therapy and Stem cell transplant.
These tests are available at MedBioTech Laboratory. Visit us for a reliable diagnosis.
References:
www.mayoclinic.org
www.medspace.com
www.nhs.uk




